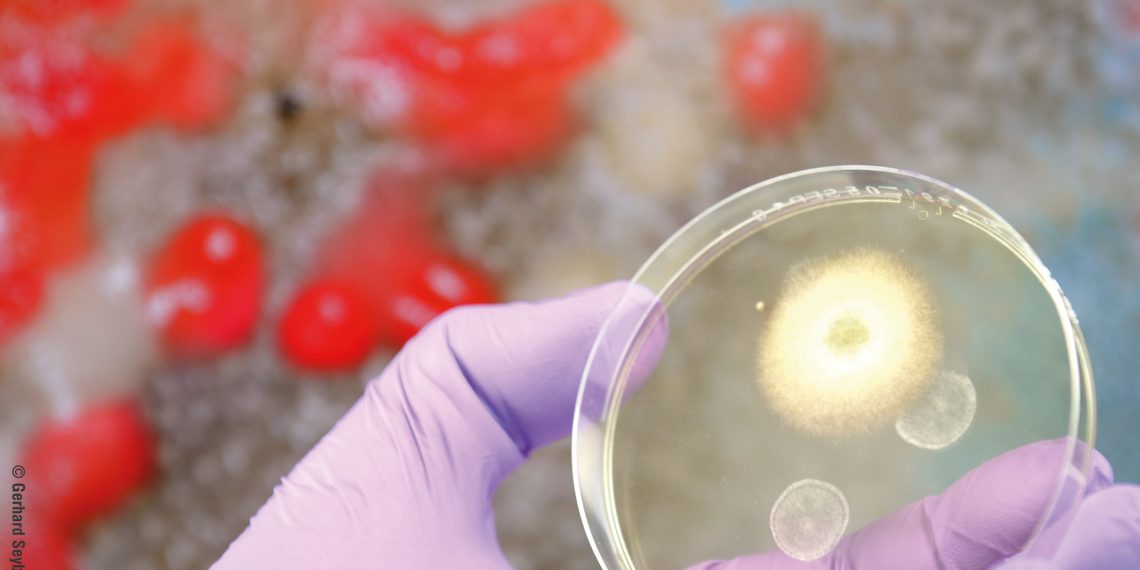

Vom 4. bis 6. April 2017 findet in Nürnberg die European Coatings Show statt. Sie ist die Weltleitmesse für die Lack- und Farbenindustrie. In diesem fachlichen Umfeld ist auch Vink Chemicals zu Hause und stellt auf der ECS seine Produkte und Dienstleistungen für die Topf- und Filmkonservierung vor. Das Unternehmen produziert anwendungsspezifische und individuelle Biozid-Formulierungen für Farben, Lacke, Kleb- und Dichtstoffe sowie für die Bauchemie.
Effektive Konservierungsmittel für die Topf- und Filmkonservierung auf Basis der aktuellen regulatorischen Anforderungen stehen im Mittelpunkt des Messeauftritts von Vink Chemicals. Das Unternehmen aus dem niedersächsischen Kakenstorf bietet alles aus einer Hand: über 100 Biozid-Formulierungen basierend auf ca. 21 bioziden Wirkstoffen und All-in-one-Service mit Laborservice, Forschung und Entwicklung, Rohstoffbeschaffung, Logistik sowie regulatorischer Beratung und Unterstützung. Im Mittelpunkt stehen bei der Biozidentwicklung neben der Wirksamkeit und Anwendungsfreundlichkeit auch Kennzeichnungsfreiheit und die Abwesenheit von sensibilisierenden und krebs- oder allergieauslösenden Stoffen. Alle notwendigen Registrierungen und Zulassungen, zum Beispiel nach der neuen Verordnung über Biozidprodukte (EU) Nr. 528/2012 übernimmt Vink Chemicals, bei Bedarf auch für den Kunden. Darüber hinaus ist das Inverkehrbringen von zugelassenen Vink-Produkten als Private Label möglich.
Biofilmbildung wirksam reduzieren
Grundlage für den effektiven Einsatz von Bioziden ist die individuelle Betriebshygieneberatung des Vink-Expertenteams vor Ort. Durch optimale Betriebshygiene kann der Einsatz von Bioziden mehr Effekt erzielen. Das spart Kosten und schont die Umwelt. Dazu gehört auch die Bekämpfung von schädlichen Biofilmen in Produktionsanlagen. Gegen Biofilme gibt es drei Strategien: Man ignoriert sie, man entfernt sie regelmäßig aufwändig oder man setzt auf die beste Strategie und reduziert durch effektive Reinigungsmaßnahmen ihre Entstehung. Dafür bietet Vink Chemicals die Systemreiniger Vinkocide SR1 und SR3 an, die bei Bedarf auch in Kombination oder zusammen mit bioziden Komponenten eingesetzt werden können. Sie werden abhängig von Materialien, Betriebsparametern und Befallsgrad verwendet und dienen dazu, die Produktionsanlagen regelmäßig zu spülen. Richtig ausgewählt und eingesetzt sorgen die Systemreiniger dafür, dass in den Produktionsprozessen für Farben und Lacke bereits geringere Keimbelastung vorherrscht. Auf dieser Basis können die erforderlichen Biozid-Formulierungen für die Produktkonservierung effizient eingesetzt werden.
Das Profiteam für richtigen Biozid-Einsatz
Die Vink Chemicals GmbH & Co.KG entwickelt und formuliert individuelle Biozide in Chargengrößen von bis zu 20 Tonnen pro Batch. 16 Spezialisten sind in Kakenstorf für den Vertrieb, den Rohstoffeinkauf, die Produktentwicklung im eigenen F&E‑Labor und für die Produktionsanlagen zuständig. Das Produktionsvolumen von 12.000 Tonnen im Jahr umfasst die komplette Palette der bekannten Biozide für die Topf- und Filmkonservierung von Farben und Lacken, aber ebenso für Wasserbehandlung, Kühlschmierstoffe, Bauchemie, Wasch‑, Reinigungs- und Desinfektionsmittel oder die Polymerindustrie. Vink Chemicals ist in Europa, Afrika und Asien aktiv.
Vink Chemicals auf der European Coatings Show 2017: Halle 1 – Stand 1–248